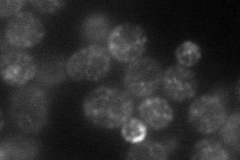
YML059C
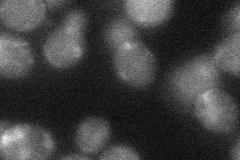
YML059C

View description
Serine esterase, homolog of human neuropathy target esterase (NTE); Nte1p-mediated phosphatidylcholine turnover influences transcription factor Opi1p localization, affecting transcriptional regulation of phospholipid biosynthesis genes
Localization:
Intensity:
Fold change:
Significance:
-
C’ GFP library in SD

ER23.85 -
N' NOP1pr-GFP in SD
punctate,bud57.4184 -
N' TEF2pr-mCherry in SD

cell periphery,punctate,bud neck38.8495 -
N' NATIVEpr-GFP in SD

below threshold19.1263 -
N' TEF2pr-VC and Cyto-VN in SD
punctate30.1849 -
C’ GFP library in SD+DTT

ER21.70.9No -
C’ GFP library in SD+H2O2

ER30.341.27No -
C’ GFP library in Starvation Media

ER23.780.99No -
C’ GFP library on the background of Pup2-DaMP

N/A -
C’ GFP library on the background of CCT mutant

N/A0N/AYes
